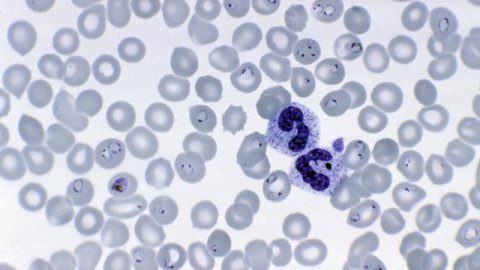
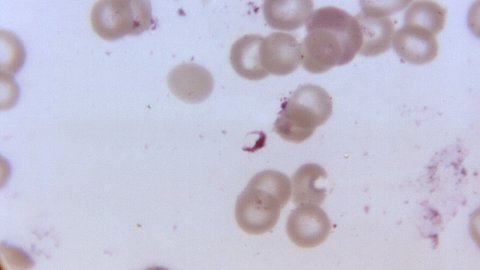

Study Groups
WWARN facilitates a number of collaborative Study Groups to undertake individual patient data meta-analyses to answer specific research questions about malaria treatments and antimalarial drug resistance. Gathering and combining data sets from multiple studies increases sample sizes, so that effects, including smaller effects, and effects on sub-populations can be identified with greater certainty. Working together and combining data from different regions and populations is improving our understanding of drug resistance and strengthening global efforts to control and eventually eliminate malaria.

i
Dominic Chavez World Bank

This Study Group aims to bring together and explore the latest evidence on the prevalence of molecular markers associated with antimalarial drug resis…
show more

The Subpatent Malaria and Pregnancy Outcome Study Group aims to explore the relationship between subpatent Plasmodium falciparum malaria inf…
show more

The sulphadoxine-pyrimethamine (SP) resistance Data Access Group’s aim is to provide maps and open access to the most recent data on molecular markers…
show more

The Alternative MiP Prevention Strategies (AMPS) Study Group’s aim is to determine the safety and efficacy of novel strategies for the control of mala…
show more

The Sulphadoxine-Pyrimethamine (SP) resistance Study Group’s aim is to provide open access to, and establish maps with, the most recent data on SP res…
show more

The Alternative MiP Prevention Strategies (AMPS) Study Group’s aim is to determine the safety and efficacy of novel strategies for the control of mala…
show more

A pooled analysis assessing the effect of mg/kg dosing strategies on the risk of treatment failure in patients treated with the currently recommended…

Modelling the protective effect of Artesunate-Amodiaquine (AS-AQ)A pooled analysis to assess the post-treatment prophylactic effect of artesunate-amod…
show more
Development of statistical methods to infer the relationship between the percentage of resistant infections, parasite clearance half-life and the prop…
show more

A pooled analysis on the relationship between K13 molecular marker and parasite clearance data. The Study Group closed to new participants in Dec…
show more

Pooled analyses of the efficacy and safety of single low-dose primaquine to interrupt P. falciparum malaria transmission.Data collection has closed an…
show more

A pooled analysis that assessed the effect of various nutritional indicators in treatment outcome in children aged 6-59 months treated with artemisini…
show more

Baseline information on parasitological response to ACTs in AsiaA pooled analysis to assess the baseline early parasitological response after artemisi…
show more

Parasite clearance after treatment with an artemisinin monotherapy or ACTThis Study Group characterises parasite clearance stratified by location, tre…
show more

Role of candidate molecular markers of lumefantrine and amodiaquine resistanceThe Artesunate-Amodiaquine/Artemether Lumefantrine (AS-AQ/AL) Molecular…

Analysis of haematological response before and after antimalarial treatment. A pooled analysis to understand the normal haematological response a…
show more
A pooled analysis of Plasmodium falciparum gametocyte carriageThe purpose of this Study Group is to assess the risk factors for treatment failure asso…
show more

A population pharmacokinetic/pharmacodynamic model of pyrimethamine and sulfadoxine in participants who received either sulfadoxine-pyrimethamine (SP)…
show more

Analysing PK/PD data to identify inadequate drug exposure and inform dosageA pooled lumefantrine pharmacokinetic-pharmacodynamic (PK/PD) analysis is b…
show more

Effect of DP mg/kg dosing strategies on the risk of treatment failureA pooled analysis to assess the impact of weight adjusted (mg/kg) dose variations…
show more

Effect of AS-AQ mg/kg dosing strategies on the risk of treatment failureA pooled analysis to assess the impact of weight adjusted (mg/kg) dose variati…
show more

The AL Dose Impact Study Group was first established in 2011. The Study Group first met in December 2011 at the ASTMH Annual Meeting to discuss the St…
show more

Baseline information on parasitological response to ACTs in AfricaA pooled analysis to assess the baseline early parasitological response after artemi…
show more

Analysing PK/PD data to identify inadequate drug exposure and inform dosageA pooled piperaquine pharmacokinetic analysed the exposure to piperaquine i…
show more

Analysing PK/PD data to identify inadequate drug exposure and inform antimalarial dosageA pooled pharmacokinetic/pharmacodynamics (PK/PD) analysis of…

